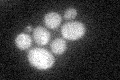
YMR234W
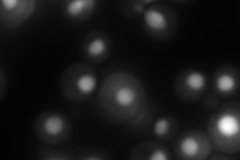
YMR234W
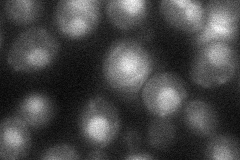
YMR234W

View description
Ribonuclease H1; able to bind double-stranded RNAs and RNA-DNA hybrids; associates with RNAse polymerase I; the homolog of mammalian RNAse HII (the S. cerevisiae homolog of mammalian RNAse HI is RNH201)
Localization:
Intensity:
Fold change:
Significance:
-
C’ GFP library in SD
below threshold17.77 -
N' NOP1pr-GFP in SD

nucleus77.4571 -
N' TEF2pr-mCherry in SD
nucleus133.836 -
N' NATIVEpr-GFP in SD

nucleus24.2553 -
N' TEF2pr-VC and Cyto-VN in SD
nucleus38.3297 -
C’ GFP library in SD+DTT

cytosol14.330.8No -
C’ GFP library in SD+H2O2

cytosol16.480.92No -
C’ GFP library in Starvation Media

cytosol24.931.4No -
C’ GFP library on the background of Pup2-DaMP

below threshold -
C’ GFP library on the background of CCT mutant

below threshold18.44391.03764No
